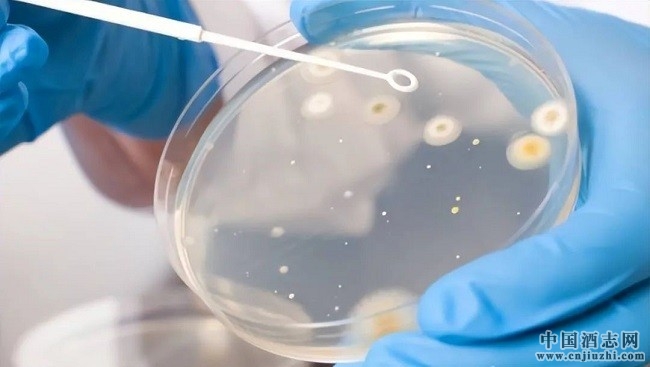
9.jpg

唯有经典,方能穿越历史沉淀而精炼,呈现一种跨越时空的智慧,尤其是名家之言,其宏达格局与前瞻性视角,让我们可站在巨人之肩,看清未来之路。——题记
在中国酒领域,没有人不知道秦含章先生的名字,而提起秦老,亦没有人不由衷生发钦佩之情。

中国酒界泰斗秦含章先生
他一生112岁,横跨晚清、北洋、民国、新中国四个年代,是新中国食品科学技术和工业发酵与酿造技术的拓荒者和学术带头人,对新中国开创以来的食品工业、酱油工业、葡萄酒工业、面包工业、白酒工业等都有奠基性贡献。尤其是中国酿酒业,曾用毕生的精力走访了超过1700家/次酒厂,并主持参与了“茅台试点”“汾酒试点”等重大攻关,参与了全国筹建十五所轻工院校的规划与教材编审,以科学化、标准化、专业化的改革,让中国酒业实现了“传统手工酿造”向“现代化酿酒科技”的转变,更成为中国酿酒业的精神丰碑,成为我国酒界、酿造界共奉的“一代宗师、酒界泰斗”。

汾酒试点期间的秦含章先生
而除了贡献与功勋之外,更令世人心生触动的,还有他作为建国后老一代科学家,所流露出的社会责任与工作态度。他曾言,“退休后,我觉得自己的思想、兴趣、爱好还没有完全表达出来,所以我要继续把我所知道的都写出来,作为我唯一的财产留给后人。”
因此,当他93岁高龄,视力已经变得很差时,仍旧使用放大镜,一字一句地坚持每天手写书稿。全文5万字的《白酒春秋——中国蒸馏酒的演变及发展趋向》就是在这样的条件下完成的,将中国酒从古至今的发展,悉数道来。


秦含章先生工作日常
此外,他的著作还有《新编酒经》《酒文化小品集》《现代酿酒工业综述》《法国发展啤酒工业的经验》《葡萄酒的科学技术》《国产白酒的工艺技术和实验方法》等。其中,《国产白酒的工艺技术和实验方法》全书高达350万字,将其毕生酿造经验荟萃其中,被酿酒技术人员奉为“酿酒操作的百科全书”,《新编酒经》则有近80万字,被誉为“中国酒文化第一书”。秦含章先生仙逝后,据统计,秦含章先生所编写、著作的书籍与文献资料,高达6000余万字、40余部。


秦含章著作
8月15日,正值“中国酒界泰斗”秦含章先生仙逝五周年,笔者重读了其部分代表性的学术作品,发现其中很多观点都极具前瞻性,可以说在如今酿酒产业中均得到一一印证,展现出秦含章先生思想的高妙深远。因此,特撰此文,总结几点,以缅怀先生遗德、表达钦佩之心,也为读者提供更多思考。
第一、科技兴酒的技艺观
1999年,秦含章先生特撰《21世纪中国食品生产的发展战略》一文,其中提到一个非常重要观点,意思是看待中国白酒,应刷新传统视角,要以生物工程的科技角度,诠释中国酒。

微生物科学实验室
文中,他提到了生物工程时代的到来,他认为:“生物工程技术已经在国际范围内应用于轻工业、医药业、农牧业、化工业、冶金业,以及能源、环保等有关行业,对国计民生起着重要的作用。细菌、酵母和霉菌的生物过程,按工业生产的规模来处理,就是微生物工程。”

气相色谱仪
而在另一篇《白酒春秋——中国蒸馏酒的演变及发展趋向》文章中,秦含章先生还提出了酿酒行业融合生物技术的实践方法,即:在生产过程中要运用细胞工程和遗传工程来选育优良的霉菌、酵母和细菌的大生产菌种;要运用酶学工程来鉴定和检测曲体的酶活性;也要运用发酵工程的操作原理来改进或提高发酵酒醅的发酵程度和发酵产物。
酿酒微生物的培养
秦含章先生将理论与实践相结合,在其任轻工业部食品发酵工业研究所所长期间,身体力行,亲自领队创建了中国工业微生物菌种保藏管理中心,设立了全国食品发酵标准化中心、全国食品与发酵工业信息中心,并建立参与出版第一本食品学科学术期刊《食品与发酵工业》。还发布白酒、酶制剂、罐头、酵母、淀粉糖、低聚肽、益生菌和食品金属包装等众多首项国家标准和行业标准。
与此同时,先生还牵头开展中国酒业生产工业化“三大试点”,即泸州试点、汾酒试点、茅台试点。其中,汾酒试点由于科研项目之多、研究之深、意义之大,被称为中国酒业发展的里程碑。在秦含章的带领下,工作组将三大任务细化为 14 个专题、49 个项目、145 次中型酿酒试验,总结和编写有关汾酒的技术资料和研究报告达100万字以上。因此,该项目于1978年荣获科学大会重大成果奖。
时至今日,这三方面生物技术,均已经成为白酒领域研究和实现高质量发展的核心,而每年所发表的顶级论文业逐渐递增,比如在2007到2010年时,关于白酒微生物的研究每年仅有一篇被SCI收录,而近几年,每年都有十几篇甚至几十篇的科研成果受到世界瞩目。
而从具体科技角度来看,目前像遗传工程中的PCR的指纹图谱分析、基因测序及系统发育分析、克隆文库、荧光原位杂交技术(FISH)、宏基因组学,以及细胞工程中的蛋白组学、代谢组学等生物工程技术,纷纷应用于白酒的生产与研发中,让人们得以进一步摸清窖泥、糟醅、大曲的微生物群落结构、多样性,以及微生物繁殖代谢与环境因子的关系、特殊功能性微生物及其产物的关联,中国白酒产品得到了前所未有的品质提升。
第二、百花齐放的产品观
科技与工艺的落脚点,最终以高质量的产品来呈现,因此,在秦含章先生多数文章与书籍中都提到了关于产品的品质要求。
比如,他《白酒春秋——中国蒸馏酒的演变及发展趋向》中指出,中国的评酒方法拥有自己的传统经验,与国外并不一致,好的白酒或名优白酒,应该从产品的“色、香、味、体、卫”5个方面来衡量。时至今日,这五字诀也仍旧是评鉴酒体质量的五大金标准。

白酒品酒
其中,“卫”指的是卫生指标,秦含章先生在文中特别解释“铅、杂醇油、糠醛、黄曲霉毒素、3,4—苯并芘等有碍人体健康的物质,应尽量减少”,由此,也让业内逐渐从酒体风格关注到食品安全问题。
而对于食品安全问题,秦含章先生也是业界提出的第一人,他曾历任第三、五、六届全国人民代表大会代表,早在第五届、第六届人大会议上,就两次提交食品卫生提案,提出了“食品安全是关乎百姓生活的头等大事”的观点。
今天,无论是白酒类还是其他食品类,安全问题早已成为关系到民生的重大问题,而在白酒产品的检测中,关于食品安全相关的物质检测越来越严格,指标也更加繁多与精细,践行着秦含章先生“无论什么时候都要让大家喝上健康酒、放心酒”的嘱托。
此外《入世后的中国酒业》一文中,秦含章先生还提到一个影响后来产品发展趋势的观点,即“百花齐放,万紫千红”,他认为,“白酒的香型是很复杂的科研问题,生产发展了,品种增多了,香型变化了,原来的简易表达方法不能完全适应了,中国名优白酒的发展方向,应是百花齐放,万紫千红”。

秦含章先生品酒日常
现如今,正如秦含章先生所预料,近十年来,中国白酒的香型创新蔚然成风,不同风格特色的兼香型、创新香型的产品层出不穷,中国白酒进入了风味时代。各酒厂吸取不同香型生产工艺之精华,结合固有的生产工艺特点,将多曲多微的发酵方式融合灵活运用,让堆积发酵、人工窖泥等特色手段推而广之,让成百上千种调味酒科学重组,进而演变出了各具特色香型品类,呈现出了一派“万紫千红,百花齐放”的白酒品类之盛。
第三、重农溯源的产业观
秦含章先生的学术造诣,虽然主要集中在轻工业、食品、酿酒等领域,但很多文章都提到了农业的重要性。这源于他儿时种田、采桑的经历,也得益于他在出国留学期间的专业特长。比如,1935—1936年,他在进入比利时国立圣布律农学院学习时候,就是在农产工业系获得了候补博士学位,两年后又获得了比利时国国授农产工业工程师学位。此后,又在比利时布鲁塞尔大学植物学院博士班学习,进修了微生物学。

酿酒高粱种植
农业与微生物工业的专业背景,让其能够站在全产业链条去审视白酒业发展的格局,他曾在《我国酿酒工业的发展战略》《21世纪中国食品生产的发展战略》等多篇文章中,提到农业对于酿酒业的品质源头要义。他认为,酿酒要做到“农工商”三结合,“农”指组织农民,指导生产优良的酿酒原料,吸收农民入股,保证农产品有一定收益,才不会发生“谷贱伤农”的老问题。农民成为酿酒企业的股东,农产品的优劣直接与酒质有关,所以种植优良品种,满足酒厂需要,必将成为自身的天职。
如今回看,这一重视农业、追根溯源的观点,领先了行业多年,也起到了指向性的战略作用。近年来,各大企业都在纷纷加码原粮基地的建设,比如,茅台、汾酒、泸州老窖、古井贡酒等都具有自己的酿酒原粮基地,甚至选育出专用酿酒的高品质高粱品种、小麦品种等,从源头开始、从粮心开始,将品质牢牢掌握在自己手中。


酿酒原料
同时,深谙“农业为重”的使命感,酒厂也将农业生产的利益放在第一位,广泛采用采用“企业+政府+公司基地+农户”的模式,实现政府税收增加、企业产值收益增加、农户收益增加的三赢局面,让中国酒业实现了更加良性的高品质发展,也承担起诸多社会责任。
一文不能尽述,除了上面的观点之外,秦含章先生还有很多值得回味反思的思考,比如,他多次提到了中国酒对于民族文化和生活情志的积极意义、中国酒要走出国门的方法、科教对于白酒人才管理的价值等等,感兴趣的读者,可追溯原稿以细读。
秦含章先生的事迹亦反映出,老一代科学家对社会发展和科技进步的不可磨灭贡献。他们不仅带给我们知识的积累与传承、技术创新与突破,还树立了一种精神的榜样,他们所具有大格局胸怀、前瞻性视野,不仅推动了科学的发展,更对社会产生了深远的影响,因为他们,我们得以改善饮食条件、提高生活质量,他们是中国科技史与新中国发展的宝贵财富。
谨以此文,怀念“中国酒界泰斗”秦含章先生的继往开来之功。(文/李 虓)














